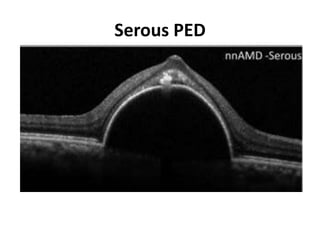
Serous PED

The document discusses retinal pigment epithelial detachments (PEDs), outlining their types, associated ocular and systemic diseases, and pathophysiology. It highlights the diagnostic methods, treatment modalities, and prognosis for patients, emphasizing the need for tailored approaches based on PED etiology. A case study illustrates the evaluation and management of a patient with a PED and age-related macular degeneration.